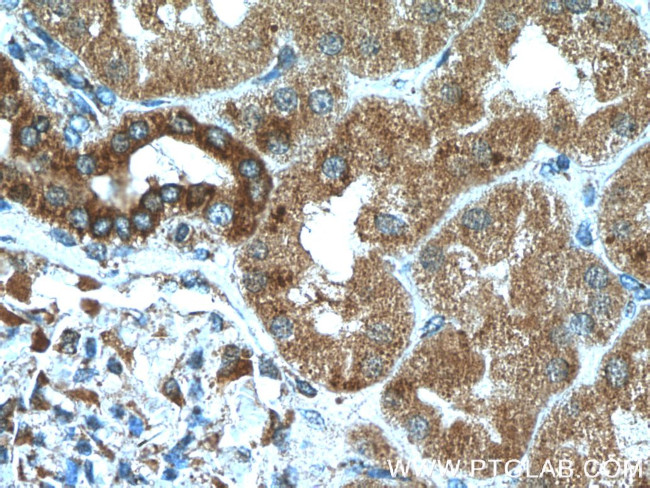
CXCR3 Antibody in Immunohistochemistry (Paraffin) (IHC (P))
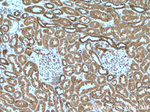
CXCR3 Antibody in Immunohistochemistry (Paraffin) (IHC (P))

Search
Proteintech
CXCR3 Polyclonal Antibody
{{$productOrderCtrl.translations['antibody.pdp.commerceCard.promotion.promotions']}}
{{$productOrderCtrl.translations['antibody.pdp.commerceCard.promotion.viewpromo']}}
{{$productOrderCtrl.translations['antibody.pdp.commerceCard.promotion.promocode']}}: {{promo.promoCode}} {{promo.promoTitle}} {{promo.promoDescription}}. {{$productOrderCtrl.translations['antibody.pdp.commerceCard.promotion.learnmore']}}
产品信息
26756-1-AP
种属反应
已发表种属
宿主/亚型
分类
类型
抗原
偶联物
形式
浓度
规格
纯化类型
保存液
内含物
保存条件
运输条件
产品详细信息
Immunogen sequence: MVLEVSDHQ VLNDAEVAAL LENFSSSYDY GENESDSCCT SPPCPQDFSL NFDR (1-53 aa encoded by BC034403)
靶标信息
CD183, also known as CXCR3, is a seven-transmembrane G protein-coupled chemokine receptor that binds CXCL9 (Mig), CXCL10 (IP-10), and CXCL11 (I-TAC), which are part of the CXC chemokine subfamily. CD183 plays a crucial role in leukocyte traffic, influencing integrin activation, cytoskeletal changes, and chemotactic migration. It is expressed on NK cells, subsets of T lymphocytes, regulatory T cells (Tregs), and is preferentially found on Th1-polarized cells. CD183 is prominently expressed in effector/memory T cells and T cells in inflamed tissues, contributing to CD4 T cell responses to grafts, as evidenced by compromised allograft rejection in CXCR3 knockout mice. Chemokine binding induces rapid, short-lived cellular responses due to receptor internalization, with responsiveness restored after receptor recycling. Inhibition by Bordetella pertussis toxin suggests coupling with Gi subclass G proteins. The production of IP-10, Mig, and I-TAC in inflammatory lesions indicates CD183 role in recruiting inflammatory cells, making it a target for developing antagonists to treat inflammatory diseases. Multiple transcript variants encoding different isoforms of CD183 have been identified.
仅用于科研。不用于诊断过程。未经明确授权不得转售。
生物信息学
蛋白别名: an; C Cmotif chemokine; C X C motif chemokine; C-X-C chemokine receptor type 3; CC motif chemokine; CCmotif chemokine; CD183; chemokine (C-X-C motif) receptor 3; chemokine (C-X-C motif) receptor 3 isoform CXCR3_1; chemokine (C-X-C motif) receptor 3 isoform CXCR3_2; chemokine receptor 3; CKR-L2; CXC; CXC motif chemokine; CXC-R3; CXCR3-B; G protein-coupled receptor; G protein-coupled receptor; G protein-coupled receptor 9; Interferon-inducible protein 10 receptor; IP-10 receptor; IP10; IP10 receptor; Mig receptor; unnamed protein product
基因别名: CD182; CD183; CKR-L2; CMKAR3; CXCR3; GPR9; IP10-R; Mig-R; MigR
UniProt ID: (Human) P49682, (Mouse) O88410
Entrez Gene ID: (Human) 2833, (Mouse) 12766